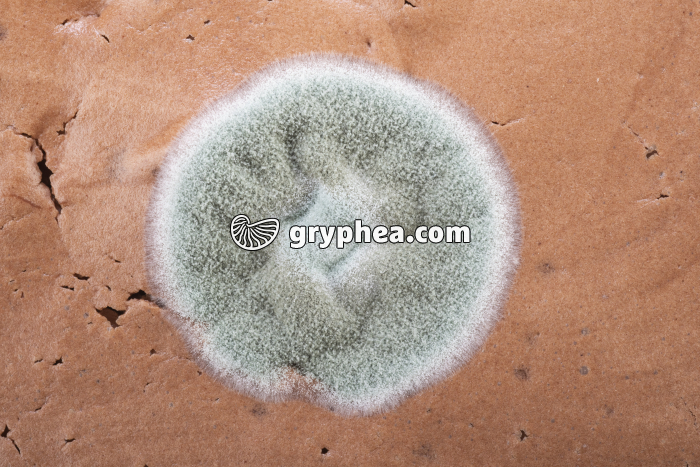
Moisissure sur mousse au chocolat - gryphea.com

1 crédit = 6.00€ TTC
(Hors pack)
si vous êtes enseignant, le site gryphea.org a été conçu spécialement pour vous !
Les Penicillium sont des moisissures courantes, dont les colonies de forme circulaire arborent une coloration bleu-vert assez caractéristique. On peut les observer sur les fruits moisis, notamment les agrumes, les confitures, le pain, mais aussi sur certains fromages, comme le Roquefort ou certains camemberts.
Les Penicillium sont des champignons particuliers, dont le système végétatif est filamenteux et les hyphes microscopiques. Leur appareil reproducteur, qualifié de conidiophore, est ramifié et ressemble à l'extrémité d’un pinceau. Au microscope, on peut observer que les spores qu'il engendre (conidies ou conidiospores) sont disposées en chaînes plus ou moins longues qui divergent les unes des autres.
Les colonies matures ont souvent aspect duveteux en surface et une teinte bleu-vert, mais sont blanches lorsqu'elles sont encore très jeunes et peu développées. Les variétés les plus communes sont répertoriées ci-dessous :
- Penicillium italicum : c'est la moisissure[...]
La suite du commentaire est réservée aux inscrits, créez un compte gratuitement.